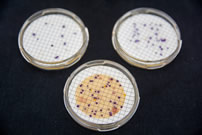

Área do laboratório: 520 m²
O Laboratório de Cubatão desempenha importante papel na Baixada Santista. Junto ao estuário e Baía de Santos, situa-se a principal área industrial e urbana do litoral paulista e o maior porto da América Latina. O laboratório, alí instalado, tem por finalidade precípua, o atendimento ao Programa de Balneabilidade das Praias, o monitoramento de rios e córregos da região e o atendimento às demandas de fiscalização e licenciamento de atividades antrópicas, visando também minimizar a carga dos laboratórios situados na matriz, em São Paulo.
Com aparelhos modernos e corpo técnico especializado, possui acreditação com base na norma ISO IEC 17025, conferida pela Coordenadoria Geral de Acreditação do INMETRO, para ensaios e amostragem, com CRL 0203.
Atende às demandas provenientes da área que se estende de Bertioga a Ilha Comprida e realiza ensaios nas áreas de Físico-quimíca e Microbilogia. Atende ainda às solicitações de clientes externos (público em geral).

Amostragem
A atividade de amostragem é realizada em conformidade com o Standard Methods for the Examination of Water and Wastewater e o Guia Nacional de Coleta e Preservação de Amostras, atendendo aos requisitos estabelecidos na norma ABNT NBR ISO/IEC 17025.
O Laboratório de Cubatão realiza amostragem de águas de consumo humano, brutas, tratadas, residuárias, salobras, salinas e areia.
Balneabilidade das Praias
O programa de balneabilidade das praias paulistas existe desde 1968, e tem como objetivo a proteção da saúde pública no que concerne às doenças de veiculação hídrica.
O Laboratório de Cubatão realiza atividades de apoio, com coletas e análises semanais das águas recreacionais da Baixada Santista e ao longo do Litoral Sul, abrangendo 70 praias e um parque ecológico. A análise da qualidade das águas das praias é realizada segundo os critérios estabelecidos na resolução CONAMA n° 274/00.

Ensaios Físico-Químicos e Microbiológicos
O Laboratório de Cubatão realiza análises microbiológicas e físico-químicas fornecendo subsídios para as ações de fiscalização de fontes de poluição, licenciamentos e renovação de licenças, monitoramento de águas superficiais e monitoramento de águas subterrâneas, além de atendimento ao público externo. Gera dados também para a emissão de relatórios e boletins de qualidade ambiental.

Ensaios Ecotoxicológicos
O teste de toxicidade aguda com a bactéria Vibrio fischeri (Sistema Microtox) é utilizado para determinar o efeito deletério de determinadas substâncias a diversos organismos vivos.

Equipamentos
Para a execução de suas atividades, com ensaios realizados em bancada e em campo, o Laboratório de Cubatão possui como principais equipamentos:
- ICP-OES – Espectrômetro de Emissão Atômica por Plasma Indutivamente Acoplado, com gerador de hidretos e nebulizador ultrassônico;
- Digestor de amostras por micro-ondas;
Cromatógrafo de fase gasosa; - Espectrofotômetros UV/VIS;
- Tituladores automáticos digitais;
- Unidades de destilação e titulação automática para ensaios de nitrogênio;
- Sistema de destilação programada para ensaios de fenóis;
- Microscópios;
- Sistema Microtox – Analisador de toxidade;
- Unidades de multiparâmetros para ensaios de pH, temperatura, condutividade e oxigênio dissolvido em campo.

EDC – Divisão de Laboratório de Cubatão
Gerente: Luciano da Silva Candido
Endereço: R. Salgado Filho, 353 – Jardim Costa e Silva
Telefone: (13) 3361-6663
Agenda: 80033
E-mail: edc_cetesb@sp.gov.br
Escopo – CRL0203